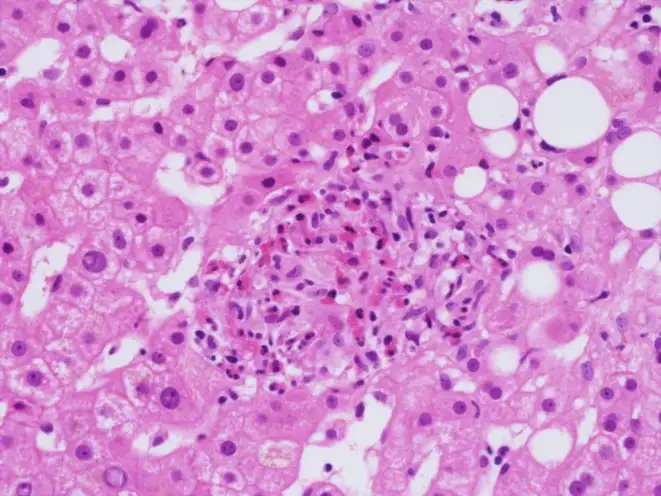
Q热肝炎患者的肝活检显示纤维环肉芽肿的组织学特征

1935年,澳大利亚昆士兰州布里斯班的一家屠宰场里,工人们开始陆续倒下。高烧、剧烈头痛、全身酸痛——这些症状看起来像是流感或伤寒,但又有所不同。疾病在工人之间蔓延,没有人知道病因是什么。当地卫生部门的微生物学家爱德华·德里克被派往调查。他不会想到,这次调查将揭开一种人类此前从未认识的致命病原体,而这种病原体日后会成为冷战时期最令人恐惧的生物武器候选者之一。
德里克花了整整一年时间研究这种神秘的发热疾病。他将患者的血液注射给豚鼠,成功复制了症状,证明了这是一种传染性疾病。但他无法找到病原体——在显微镜下什么也看不见,培养皿里什么也长不出来。这让他感到深深的挫败。他最终将这种疾病命名为Q热,Q代表"疑问"(Query),因为他对这个疾病的太多方面都一无所知。
德里克联系了墨尔本沃尔特和伊丽莎·霍尔研究所的马克法兰·伯内特寻求帮助。伯内特是澳大利亚最杰出的病毒学家之一,日后将因免疫耐受理论获得诺贝尔生理学或医学奖。在收到德里克寄来的感染组织样本后,伯内特和他的助手梅维斯·弗里曼仅仅用了几周时间就有了突破性发现。当伯内特将感染组织切片置于显微镜下时,他看到了一种"模糊的鲱鱼骨图案"——微小的杆状结构排列成行,像是一种立克次体,又像是一种"大病毒"。这是那种罕见的、可以精确到某一天某一刻的科学发现。伯内特后来在自传中写道,研究者们面对这一景象时感到"巨大的喜悦"。
这种病原体最终被命名为伯内特考克斯氏体(Coxiella burnetii),以纪念伯内特和美国科学家赫勒尔德·考克斯的贡献。它不是病毒,也不是典型的立克次体,而是一种独特的细胞内寄生细菌。德里克和伯内特的合作被伯内特后来称为"澳大利亚传染病史上最重要的医学发现"。具有讽刺意味的是,伯内特本人成为了历史上第一个有记录的Q热实验室感染者——1937年1月,他在处理病原体时意外感染,幸运地康复了。

伯内特考克斯氏体拥有一个令人毛骨悚然的特性:它是地球上最具感染力的病原体之一。根据美国军方在1950年代进行的人体实验数据,仅需吸入约15个细菌就能让一半的暴露者感染,而单个细菌就有可能在5%的暴露者身上引发疾病。这意味着什么?一个喷嚏、一阵微风、一把沾染的尘土,就足以让人命悬一线。作为对比,肺鼠疫需要吸入约100到500个细菌才能造成感染,炭疽需要吸入约8000到10000个孢子。Q热的感染剂量之低,在细菌性病原体中几乎无出其右。
这种细菌的形态本身就充满了进化的狡诈。它存在两种形态:大细胞变异体(LCV)和小细胞变异体(SCV)。大细胞变异体是活跃的代谢形态,在宿主细胞内疯狂复制;小细胞变异体则是休眠形态,像一颗微小的孢子,可以在极端环境中存活数年甚至数十年。这种小细胞变异体对热、干燥、紫外线和许多消毒剂都有极强的抵抗力。它可以在干燥的土壤中存活数年,随风飘散数公里,仍然保持感染性。当一个农场发生感染动物流产后,病原体可以随着尘埃在干燥炎热的天气里传播到下风向数公里外的社区。
当伯内特考克斯氏体进入人体后,它的入侵策略堪称完美。它主要通过呼吸道进入,被肺泡巨噬细胞吞噬——这本应是免疫系统的第一道防线,但这种细菌却将吞噬作用变成了入侵的通道。细菌进入巨噬细胞后,被包裹在一个叫做吞噬体的膜结构中。正常情况下,吞噬体会与溶酶体融合,溶酶体内的酸性环境和消化酶会将入侵者彻底摧毁。但伯内特考克斯氏体进化出了一个惊人的对策:它不仅不逃避这种融合,反而主动促进它。它需要的正是溶酶体的酸性环境。
这种细菌携带的酸性磷酸酶可以中和吞噬体的杀伤性物质,同时它利用宿主细胞的营养在酸性的吞噬溶酶体中繁殖。这个特殊的结构被称为"考克斯氏体包含泡"(CCV)。在这个改造过的细胞器内,细菌开始疯狂复制。它们会产生一种特殊的Dot/Icm型IV型分泌系统,向宿主细胞注射数百种效应蛋白,操纵宿主细胞的信号通路,阻止细胞凋亡,确保自己的生存和繁殖。当细菌数量达到一定程度时,包含泡会膨胀到几乎充满整个宿主细胞,最终导致细胞破裂,释放出数百个新的细菌,每个都可以感染新的细胞。
感染的潜伏期通常为两到三周,但也可能短至数天或长达数月。急性Q热的症状变化多端,这也是它难以诊断的原因之一。大约一半的感染者完全没有症状,仅能通过血清学检测发现抗体阳转。有症状的患者通常表现为高热、剧烈头痛、肌肉酸痛、咳嗽和全身不适。部分患者会发展为肺炎,胸部X光片可能显示多叶性浸润。另一些患者会表现为肝炎,肝脏肿大、转氨酶升高。还有一些患者会出现心肌炎、心包炎或脑膜炎。正是因为症状如此多样,Q热被称为"伟大的模仿者"之一。

在抗生素出现之前的时代,Q热的病死率约为1%到2%。如今,及时使用多西环素治疗后,病死率已降至极低。但问题在于,由于症状缺乏特异性,许多Q热病例从未被正确诊断,患者可能被当作流感、非典型肺炎或不明原因发热处理,自然康复后终身不知道自己曾经与这种致命病原体搏斗过。
然而,Q热真正令人恐惧的并非急性期,而是它的慢性化。大约1%到5%的急性感染者在数月甚至数年后会发展为慢性Q热,这是一种完全不同的疾病。病原体在体内潜伏,等待机会,最终在一些特定的部位——通常是心脏瓣膜——建立慢性感染。慢性Q热心内膜炎是最常见也最致命的表现。它发展缓慢、隐匿,患者可能只是感到疲劳、体重下降、低热、关节痛,这些症状被归咎于其他原因,直到心脏瓣膜被严重破坏。
慢性Q热心内膜炎的病死率令人震惊:未经治疗的患者,病死率高达25%到60%。即使接受治疗,患者也需要服用抗生素长达18个月到数年,甚至终身。治疗方案通常是多西环素联合羟氯喹,后者可以碱化吞噬溶酶体,削弱细菌的酸性生存优势。这种治疗可以显著降低病死率,但副作用也不容忽视——长期服用多西环素可能导致光敏性皮疹和牙齿变色,羟氯喹则有视网膜毒性的风险。
更令人不安的是,慢性Q热可能在感染数十年后才出现症状。有报道记录了患者在急性感染后20年才发展为心内膜炎的案例。这意味着,那些曾在某个不知名的时刻感染过Q热的人,体内可能潜伏着一个定时炸弹,等待着免疫系统减弱或其他触发因素的出现。

Q热的传播链条同样充满了意外的转折。它的天然宿主范围极广,包括牛、羊、山羊、猫、狗、啮齿动物、鸟类甚至蜱虫。但在人类感染中,最重要的来源是反刍动物——尤其是山羊和绵羊。感染动物通常不表现明显症状,但怀孕动物可能发生流产。流产的胎儿、胎盘和羊水中含有天文数字级别的病原体——每克组织可能含有十亿个细菌。当这些物质干燥后,病原体随着尘埃漂浮在空气中,可以被风吹到数公里之外。
这就是为什么Q热爆发往往发生在远离农场的社区。2007年到2010年发生在荷兰的Q热大爆发,是人类历史上最大规模的Q热疫情,其传播模式完美地展示了这种疾病的独特威胁。
荷兰南部本来并不是Q热的高发区。但在2005年,两个奶山羊农场报告了山羊流产的问题。当时,没有人意识到这是即将到来的灾难的前兆。2007年,人类Q热病例开始出现在这些农场附近的社区。2008年,病例数量急剧上升。2009年,疫情达到高峰,仅这一年就报告了2354例确诊病例。整个疫情期间,荷兰共报告了超过4000例确诊的人类Q热病例,至少25人死亡。但真实数字可能远高于此——许多轻症患者从未就医或被误诊。
调查显示,疫情起源于规模化奶山羊农场的"流产风暴"——大量怀孕山羊同时流产,释放出大量的病原体。这些农场位于人口密集的地区,干燥多风的天气将感染性尘埃吹向周围的城镇和村庄。在疫情最严重的地区,感染风险与居住地距离农场的距离直接相关。气象数据分析显示,每当风速和风向将农场下风带的尘埃吹向人口密集区,数周后就会出现病例高峰。
面对不断升级的疫情,荷兰政府做出了一个惊人的决定:宰杀。从2009年12月到2010年6月,政府下令宰杀了超过50000只怀孕的山羊和绵羊——这是欧洲和平时期最大规模的动物扑杀行动之一。整个奶山羊产业遭受了毁灭性打击,经济损失估计高达数亿欧元。但这项措施是否有效?至今仍有争议。病例数在2010年后确实大幅下降,但这可能也与政府同时实施的其他措施有关:对农场进行强制检测、禁止动物运输、对感染农场进行消毒、要求高风险职业人群接种疫苗。
这场爆发也揭示了Q热防控中的一个核心困境:即使是专业的防控人员也难以避免感染。在对感染农场进行扑杀工作的517名工人中,有17.5%在扑杀过程中血清阳转——这意味着他们从阴性变成了阳性——尽管他们被要求穿戴个人防护装备。那些工作时间长、在畜舍内部工作的人风险最高。这项研究让公共卫生专家认识到,在处理Q热感染动物时,个人防护装备可能不足以提供完全的保护。

Q热的历史中还有一个更加黑暗的篇章——它与生物武器的密切关联。正是因为其极高的感染性和环境稳定性,伯内特考克斯氏体从1950年代起就被美国军方列为潜在的生物武器候选者。在马里兰州的德特里克堡,美国陆军开展了代号为"白大褂行动"(Operation Whitecoat)的生物防御研究项目。从1954年到1973年,超过2300名志愿者的健康青年参与了这项实验,他们大多是基督复临安息日会教徒,因宗教信仰而拒绝服兵役,选择作为非战斗人员参与医学研究。
在这些实验中,志愿者被暴露于各种病原体,包括Q热、土拉菌病、黄热病等。他们被安置在一个巨大的不锈钢球体内,通过管道吸入已知剂量的病原体气溶胶。Q热是测试最多的病原体之一。正是这些人体实验提供了关于Q热感染剂量的精确数据——15个细菌就能感染一半的暴露者。这些数据至今仍是制定生物安全标准和公共卫生指南的基础。
这些实验在当时的伦理框架下进行,志愿者被充分告知风险并签署了知情同意书。但这仍然是一段复杂的历史——医学研究的进步与人体实验的伦理边界在这里交织。许多志愿者后来表示,他们为自己的贡献感到骄傲,认为这有助于保护国家免受生物武器的威胁。但也有人对当年的实验提出了质疑。
1969年,美国总统尼克松宣布终止美国的进攻性生物武器项目,所有库存的生物制剂被销毁。但伯内特考克斯氏体作为B类生物恐怖制剂的地位被保留至今——这意味着它虽然不如炭疽或天花那样致命,但由于其高感染性和环境稳定性,仍可能被用于恐怖袭击。一份被泄露的文件显示,日本奥姆真理教曾至少十次尝试获取并使用包括Q热在内的病原体进行恐怖袭击,幸好均未成功。
Q热的诊断一直是临床实践中的一大挑战。传统的血清学检测——间接免疫荧光法——需要等待抗体产生,通常在发病后2到4周才能检测到。这导致了诊断的延误。更复杂的是,伯内特考克斯氏体存在两种抗原相:相I和相II。急性感染时,抗相II抗体率先升高;慢性感染时,抗相I抗体占主导。这种独特的免疫学特征可以帮助区分急性和慢性感染,但需要经验丰富的实验室人员正确解读。
分子诊断方法如聚合酶链反应(PCR)可以更早地检测到病原体的DNA,但伯内特考克斯氏体在培养时具有极高的传染风险,因此只能在生物安全三级实验室中进行常规操作。这也是为什么许多医院和实验室不具备Q热诊断能力的原因之一。
在治疗方面,急性Q热的首选药物是多西环素,疗程通常为14天。早期治疗可以显著缩短病程和降低并发症风险。但对于已经发展为慢性感染的患者,治疗则要复杂得多。慢性Q热心内膜炎需要至少18个月的多西环素联合羟氯喹治疗,部分患者可能需要手术更换受损的瓣膜。即使如此,复发率仍然不低,一些患者需要终身用药。
疫苗是预防Q热的最佳手段,但人类疫苗的供应极为有限。澳大利亚开发了一种名为Q-Vax的疫苗,对高危人群(如屠宰场工人、兽医、农场工人)的保护效果超过95%。但这种疫苗需要在接种前进行皮肤测试和血清学筛查,以排除曾经感染过的人——因为在已免疫的个体中接种可能导致严重的局部反应。由于这些限制,Q-Vax的使用范围一直很窄,在大多数国家甚至无法获得。
在动物疫苗方面,情况稍好一些。一种用于山羊和绵羊的灭活疫苗已被证明可以减少流产和细菌脱落,从而降低人类感染风险。荷兰在疫情后强制要求高风险农场的动物接种疫苗,这被认为是控制疫情的重要措施之一。
但Q热的威胁远未消失。在全球范围内,这种疾病被严重低估和漏报。许多国家缺乏Q热的监测系统,医生对这种疾病知之甚少。随着全球气候变化,干旱和极端天气事件增多,感染性尘埃的传播可能变得更加普遍。规模化畜牧业的发展也为Q热的传播创造了新的条件——高密度的动物群体意味着一旦发生感染,病原体可以迅速扩散。
从澳大利亚屠宰场的神秘发热开始,Q热的故事跨越了近一个世纪,涉及科学发现、战争与和平、医学伦理和公共卫生。这种以"疑问"命名的疾病,至今仍然留给我们许多未解之谜:它的确切自然宿主是什么?为什么有些人会发展为慢性感染而另一些人不会?我们能否开发出更安全、更有效的疫苗?气候变化将如何影响它的传播模式?
伯内特考克斯氏体是一种完美的寄生者——它不需要杀死宿主就能传播,它在环境中几乎不死,它需要的剂量微乎其微。在某种意义上,它是人类与微生物之间永恒博弈的一个缩影,提醒我们:我们从未真正征服自然界,我们只是在不断适应和学习。而那些以"疑问"命名的事物,往往隐藏着最深刻的答案。
参考资料
-
Derrick EH. Q fever, a new fever entity: clinical features, diagnosis and laboratory investigation. Medical Journal of Australia. 1937;2:281-299.
-
Burnet FM, Freeman M. Experimental studies on the virus of “Q” fever. Medical Journal of Australia. 1937;2:299-305.
-
Brooke RJ, Kretzschmar ME, Mutters NT, Teunis PF. Human dose response model for Q fever. Epidemiology & Infection. 2017;145(10):2124-2131.
-
Roest HI, Tilburg JJ, van der Hoek W, et al. The Q fever epidemic in The Netherlands: history, onset, response and reflection. Epidemiology & Infection. 2011;139(1):1-12.
-
Whelan J, Schimmer B, Schneeberger P, et al. Q fever among culling workers, the Netherlands, 2009-2010. Emerging Infectious Diseases. 2011;17(9):1710-1712.
-
Anderson A, Bijlmer H, Fournier PE, et al. Diagnosis and management of Q fever—United States, 2013. MMWR Recommendations and Reports. 2013;62(3):1-30.
-
Maurin M, Raoult D. Q fever. Clinical Microbiology Reviews. 1999;12(4):518-553.
-
Omsland A, Beare PA, Hill J, et al. Isolation from animal tissue and genetic transformation of Coxiella burnetii are facilitated by an improved axenic growth medium. Journal of Bacteriology. 2011;193(21):5786-5791.
-
Mcquiston JH, Holman RC, McCall CL, et al. National surveillance and the epidemiology of human Q fever in the United States, 1978-2004. American Journal of Tropical Medicine and Hygiene. 2006;75(1):36-40.
-
Van der Hoek W, Dijkstra F, Schimmer B, et al. Q fever in the Netherlands: an update on the epidemiology and control measures. Eurosurveillance. 2010;15(12):19520.